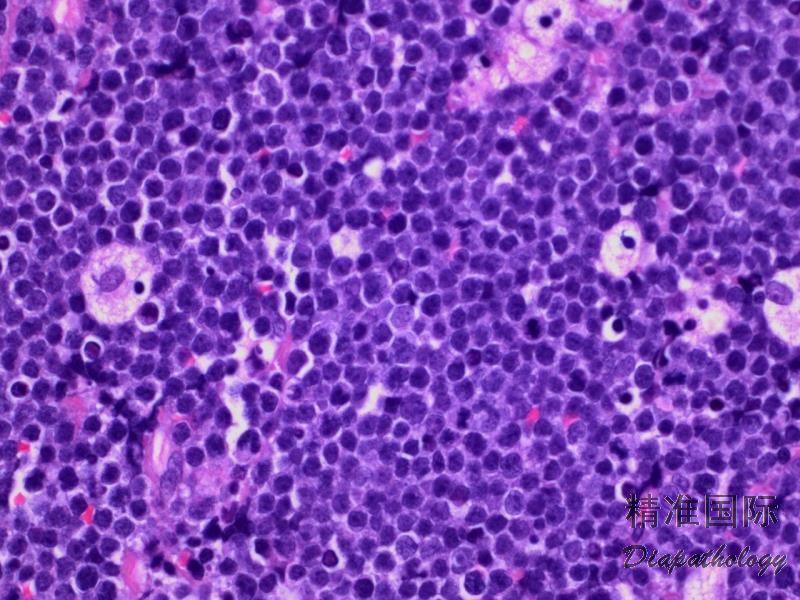

Burkitt 淋巴瘤
Burkitt Lymphoma, BL
概述:
BL 是一种 B 细胞淋巴瘤,生长快速,具高度侵袭性。常发生在结外,但也累及骨髓,表现为急性白血病。肿瘤细胞中等大小,形态一致。MYC 基因易位是其特征性遗传改变。极少数病例检测不到 MYC 基因易位,其中有的 11q 异常(见下亚型)。
诊断要点:
发病年龄从儿童到成人不等,取决于临床亚型(见下)。男性多见,多数表现为快速增大结外肿块或白血病。发病部位也根据临床亚型有所不同。
肿瘤细胞弥漫生长,很多核分裂和凋亡细胞,或有坏死区域。大量散在组织细胞吞噬凋亡细胞核碎片,呈现特征性“星空”现象。
肿瘤细胞中等大小,与组织细胞核相近,从形态到大小都高度一致。胞核圆形或稍椭圆形,染色质粗块状,可见多个核仁。胞质中等量,强噬碱性。细胞之间紧密接触,常导致胞质形成方块倾向。在染色的涂片或触印片上,胞质含有很多脂质空泡。
免疫组化:表达全 B 细胞抗原 CD20. CD79a、PAX5,CD10+,Bcl-6+,Bcl-2-,CD5-,cyclin D1-,TdT-,CD34-,Ki67 分裂指数几乎 100%。EBER 不同程度阳性(见下)。T 细胞(CD3+))非常稀少。
流式:B 细胞抗原(CD20,CD19)阳性并表达 CD10,轻链限制性表达。TdT-,CD34-。
遗传学(染色体或 FISH):MYC 基因异常包括 t(8;14)(80%)、t(8;22)(15%)、或 t(2;8)(5%), 但无 BCL-2 和 BCL6 基因异位。此外,可有其它染色体异常(获得或丢失)及体细胞基因突变如 TCF3。
Ig 基因克隆性重排。
亚型
临床亚型:
地方型:主要在赤道非洲,大多数为 4-7 岁儿童。约 50%发生在淋巴结外,尤其是在下颌和眼眶,但累及骨髓白血病现象少见。几乎所有病例 EBER+。
散发型:此型很少累及面部结构,绝大多数患者表现为腹部消化道受累。侵犯骨髓较地方型多见。20%病例 EBER+。
免疫缺陷相关型:见于 HIV 患者,通常处在疾病进展期,作为初诊 AIDS 的证据。累及淋巴相对常见,也可累及结外组织如胃肠道、骨髓和中枢神经系统。
形态学亚型:
Burkitt 淋巴瘤伴浆细胞样形态:见于 HIV 相关病例。细胞大小和形态不如经典型那样均一,胞核偏位,如浆细胞样改变,但免疫表型和遗传学符合典型的 Burkitt 淋巴瘤。
Burkitt 样淋巴瘤伴 11q 异常(Burkitt-Like Lymphoma with 11q Aberration):在 2107 版 WHO 中列为一新疾病实体,故不能算作真正 Burkitt 淋巴瘤的变异型。肿瘤形态学符合 Burkitt 淋巴瘤,但细胞可能有些多型(甚至偶见滤泡),免疫表型也大多符合,但无 MYC 基因易位,而有 11q 异常。累及淋巴结较常见。临床过程与 Burkitt 淋巴瘤相似。除此之外,约 10%Burkitt 淋巴瘤病例检测不到 MYC 易位,除部分病例属于 Burkitt 样淋巴瘤伴 11q 异常外,其余病例是由于技术原因还是有真正的无 MYC 基因易位的 Burkitt 淋巴瘤,目前尚无定论。

鉴别诊断:
- 淋巴母细胞淋巴瘤 :肿瘤细胞中等大小,较均一,但核不成熟,核仁不明显,胞浆少,“星空”现象也不突出。B-LB 一般不表达或弱表达 CD20,但表达 CD79a、PAX5. CD19,T-LBL 表达胞浆 CD3 及 T 相关抗原。TdT+,CD34+。
- 弥漫性大 B 淋巴细胞瘤 :“星空”少见。细胞较大,形态大小相对不均一,形态如中心母细胞或免疫母细胞。Bcl-2 常阳性,分裂指数一般<90%。少数病例有 MYC 易位,但多伴有其它染色体异常。
- 高级别B细胞淋巴瘤** **,非特指:特征介于 DLBCL 和 BL 之间的“灰区淋巴瘤”。有些病例形态学类似 BL 但免疫表型不符合如 BCl-2+;另一些病例免疫表型与 BL 一致,但形态学不符合,如细胞较大且多形性。可以有 MYC 基因易位,但同时有 MYC、BCL2 或 BCL6 基因易位(“双打击”)的病例不属此类。
- 高级别B细胞淋巴瘤伴 MYC、BCL2 或 BCL6 基因易位 :这类病例形态学和免疫表型可以类似弥漫大 B 细胞淋巴瘤或特征介于 DLBCL 和 BL 之间的高级别 B 细胞淋巴瘤或类似 Burkitt 淋巴瘤 ,但同时有 MYC 和 BCL2 或同时有 MYC 和 BCL6 或同时有 MYC、BCL2 和 BCL6 基因易位(“双打击”、“3 打击”)。
- 母细胞亚型套细胞淋巴瘤 :细胞形态大小一致,可出现“星空”现象,核分裂多见,与 BL 有些相似,但表达 CD5 和 cyclin D1。少数有继发 MYC 基因易位,但同时有 CCND1/IgH 易位。
